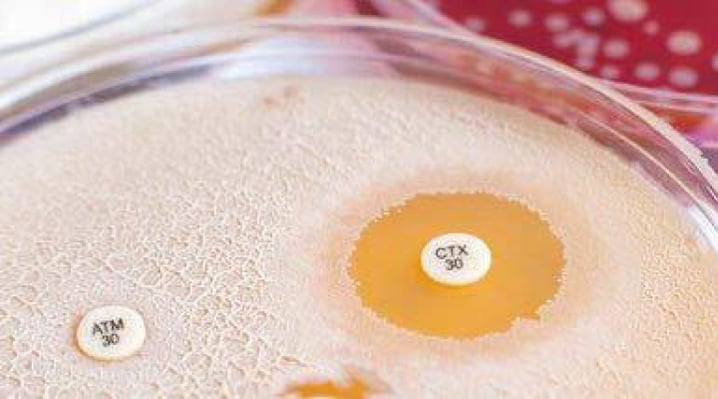
spotlight_science_3

In reality, the primary advantage of this automation in the clinical laboratory where the study was conducted lies less in cost savings but more in increased productivity.
– JR Caldera et. al. https://doi.org/10.1016/j.jmoldx.2024.05.006
See how the MagicPrep NGS simplifies library prep by reducing hands-on time to 10 hours instead of 2 days, and contributes to the development of targeted therapies in childhood ALL.

Explore how the MagicPrep NGS platform accelerates the research timeline by two weeks, empowering TAILΦR Labs to swiftly tackle the ever-changing landscape of bacterial infections.

Complex workflows and limited resources have hampered the widespread adoption of NGS. Learn how MagicPrep NGS opens the door to implementation of NGS by automating the library preparation process.
Everyone knows that preparing NGS libraries is a long and tedious process. Let MagicPrep NGS deal with the library prep while you focus on your priorities and accelerate your research.
The MagicPrep NGS system seamlessly integrates everything needed for automated NGS library preparation. Eliminate concerns about consumables, reagents, scripting, or optimization and simply add your samples, insert pre-filled cartridges into the instrument, and start the run. With complete walk-away automation, take back your time and let the MagicPrep NGS system make your libraries.
Streamline your library prep and productivity – the Magic way.
Reduce hands-on time to just 10 minutes
Automated with Tecan cartridge-based reagents and pre-programmed scripts, this turnkey solution allows easy and fast loading of samples and running of the workflow.
INCREASED REPRODUCIBILITY
MagicPrep NGS makes it easier than ever to create consistent and reproducible libraries ready for quantification sequencing on Illumina sequencing platforms.
COMPLETE REAGENTS AND CONSUMABLES
MagicPrep NGS kits incorporate all the advantages of Tecan’s manual kits formatted for use on the MagicPrep instrument. Saving hours of hands-on time and ensuring a high-quality library every time.
Cartridge-based reagents and pre-programmed scripts enable a turnkey solution that minimizes hands-on time and errors. MagicPrep NGS utilizes Tecan reagents for reliable, high-quality NGS library preparation. Versatile pre-scripted workflows and reagents enable a broad range of applications for maximum utility of the MagicPrep NGS system, with more applications coming soon!
.jpeg?width=1992&height=755&name=MagicPrep%20landing%20page%20update%20(2).jpeg)
Compared to the boring, time-consuming process of manual library preparation, the MagicPrep NGS system provides a fully automated and reliable solution with only 10 minutes of hands-on time. Watch this virtual demonstration to see how easy automated library preparation can be!
Start optimizing your processes today.
Provide your contact information, and our experts will be in touch soon.
*For research use only. Not for use in diagnostic procedures.